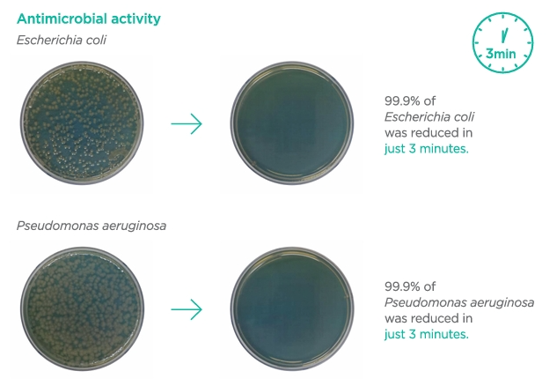

- A waterless pet cleanser that does not require a separate rinse
- 3 minute special care waterless cleanser with Jeju mineral lava water and natural extracts
- For WHOLE BODY except face
- A waterless pet cleanser that does not require a separate rinse
- Cleansing
- Moisturizing
- Skin protection
- Calm skin and coat
- pH 7 with antimicrobial activity= E.coli and pseudomonas reduced in 3mins
Cleanser that does not require a separate rinse
- Made in Korea
Paw in Clean Waterless Pet Cleanser 200ML
Regular price
₱750.00
Tax included.
PLPD-W4869
Adding product to your cart
Description
Heading
Add Second tab description here.

Paw in Clean Waterless Pet Cleanser 200ML
Regular price
₱750.00